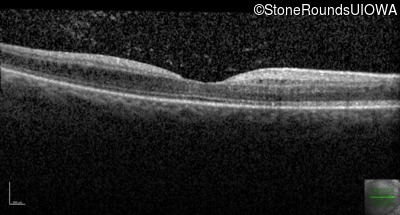
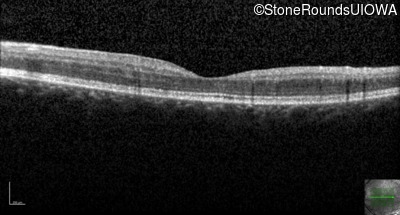

Case
SR67
Student Mode
Enhanced S-Cone Syndrome (IA2fiv)
Female
Female
Hidden
SR67
Student Mode
Enhanced S-Cone Syndrome (IA2fiv)
Female
Female
History
This 18 year old woman has had slightly subnormal acuity and high hyperopia since age 5. Her symptoms of night blindness are weak at best.
Diagnosis & molecular findings
| Disease | Gene | Allele 1 variant(s) | Allele 2 variant(s) | Inheritance mode |
|---|---|---|---|---|
| Enhanced S-Cone Syndrome | NR2E3 | IVS1-2 A>C | Arg76Trp CGG>TGG | AR |
Disease:
Gene:
Allele 1:
IVS1-2 A>C
Allele 2:
Arg76Trp CGG>TGG
Inheritance:
AR